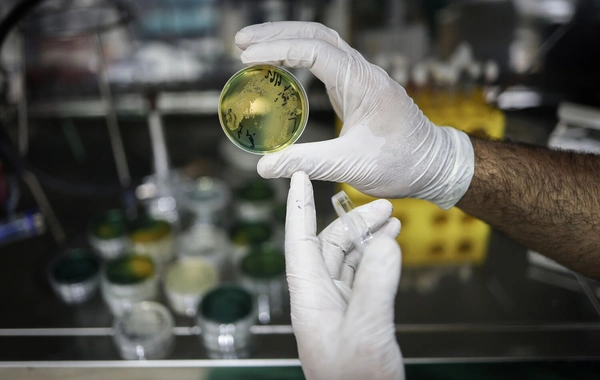

1 iyul 2024-cü ildən etibarən Oxu.az mobil tətbiqinin köhnə versiyasına dəstək dayandırılacaq - yenilənmiş versiyanı endirmək üçün Google Play və ya AppStore-a keçməyiniz xahiş olunur.
Alimlər 10 müxtəlif antibiotikə qarşı davamlılıq göstərən vəba ştamı müəyyən ediblər.
Oxu.Az xəbər verir ki, bu barədə Paster İnstitutunun Vibrion və Vəba üzrə Milli İstinad Mərkəzinin alimləri məlumat yayıblar. Tədqiqatların nəticələri "New England Journal of Medicine' (NEJM) jurnalında dərc edilib.
Məlumata görə, "Vibrio cholerae" adlanan təhlükəli ştam ilk dəfə 2018-2019-cu illərdə Yəməndə baş verən vəba epidemiyası zamanı aşkarlanıb. Bakterial genomların sekvensləşdirilməsi metodu tədqiqatçılara ştamın ölkələr arasındakı yolunu və yayılmasını dəqiq izləmək imkanı verib.
Yəməndən sonra bu ştam 2022-ci ildə Livanda, 2023-cü ildə isə Keniyada qeydə alınıb. 2024-cü ilə qədər ştam Tanzaniya, Komor adaları və Fransanın Mayotta adasına da yayılıb. 2024-cü ilin mart ayından iyul ayına qədər Mayotta adasında bu ştamın səbəb olduğu 221 vəba hadisəsi qeydə alınıb.
Xüsusi narahatlıq doğuran məqam odur ki, bu ştam vəbanın müalicəsində istifadə olunan iki əsas antibiotik - azitromisin və siprofloksasinə qarşı davamlılıq nümayiş etdirir. Əgər o, tetrasiklinə qarşı da davamlılıq qazanarsa, xəstəliyin effektiv müalicəsi əhəmiyyətli dərəcədə çətinləşəcək.
Ekspertlər vəba törədicilərinin antibiotiklərə qarşı davamlılığında baş verən dəyişikliklərin vaxtında aşkarlanması üçün gücləndirilmiş qlobal monitorinqin vacibliyini vurğulayıblar. Onların fikrincə, bu təhdidlərə operativ reaksiya vermək və genişmiqyaslı epidemiyaların qarşısını almaq mümkündür.